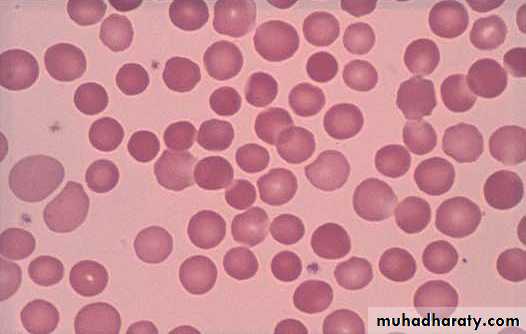

Hemolytic Anemia
• Hemolysis is defined as the premature destruction of red blood cells (RBCs).• Anemia results when the rate of destruction exceeds the capacity of the marrow to produce RBCs. Normal RBC survival time is 110–120 days. During hemolysis, RBC survival is shortened, the RBC count falls, erythropoietin is increased, and the stimulation of marrow activity results in heightened RBC production. This is reflected in an increased percentage of reticulocytes in the blood. Thus, hemolysis should be suspected as a cause of anemia if an elevated reticulocyte count is present.
• The reticulocyte count also may be elevated as a response to blood loss or for a short period after replacement therapy for iron, vitamin B12, or folate deficiency.
Several plasma, urinary, or fecal chemical alterations reflect the presence of hemolysis
Accelerated Hemoglobin Catabolism• Increased unconjugated bilirubin.
• Increased lactic acid dehydrogenase in serum.
• Increased fecal and urinary urobilinogen.
• Increased rate of carbon monoxide production.
• Hemoglobinuria
• Low or absent plasma haptoglobin.
• Raised plasma hemoglobin level .
• Raised plasma methemalbumin
• Raised plasma methemoglobin (oxidized free plasma hemoglobin) .
Increased Erythropoiesis
• 1. Reticulocytosis.
• 2. Erythroid hyperplasia of the bone marrow
3. Expansion of marrow space in chronic hemolysis resulting in:
• Prominence of frontal bones
• Broad cheek bones
• Widened intratrabecular spaces, hair-on-end appearance of skull radiographs
hair-on-end appearance of skull
Hemolytic anemias may be classified as
(1) cellular, resulting from intrinsic abnormalities of the membrane, enzymes, or hemoglobin
(2) extracellular, resulting from antibodies, mechanical factors, or plasma factors.
• Hereditary Spherocytosis
• It is the most common inherited abnormality of the red blood cell (RBC) membrane. Hereditary spherocytosis has been described in most ethnic groups, but is most common among persons of Northern European origin.ETIOLOGY
• Hereditary spherocytosis usually is transmitted as an autosomal dominant and, less frequently, as an autosomal recessive disorder.• 25% of patients have no previous family history( most represent new mutations)
• The most common molecular defects are abnormalities of spectrin or ankyrin, which are major components of the cytoskeleton responsible for RBC shape.
• The loss of membrane surface area without a proportional loss of cell volume causes sphering of the RBCs and an associated increase in cation permeability. The decreased deformability of the spherocytic RBCs impairs cell passage from the splenic cords to the splenic sinuses, and the spherocytic RBCs are destroyed prematurely in the spleen.
• CLINICAL MANIFESTATIONS
• -Hereditary spherocytosis may be a cause of hemolytic disease in the newborn and may present as anemia and hyperbilirubinemia sufficiently severe to require phototherapy or exchange transfusions.• -The severity of symptoms in infants and children is variable. Some children remain asymptomatic into adulthood, but others may have severe anemia, with pallor, jaundice, fatigue, and exercise intolerance.
• After infancy, the spleen is usually enlarged, and pigmentary (bilirubin) gallstones may form as early as age 4–5 yr.
Severe cases may be marked by expansion of the diploë of the skull and the medullary region of other bones, but to a lesser extent than in thalassemia major.
• Complications
• 1. Hemolytic crisis: With more pronounced jaundice due to accelerated hemolysis (may be precipitated by viral infection).
• 2. Aplastic crisis: Dramatic fall in hemoglobin level (and reticulocyte count); usually due to maturation arrest and often associated with parvovirus B19 infection.
• 3. Folate deficiency: Caused by increased red cell turnover; may lead to superimposed megaloblastic anemia. Megaloblastic anemia may mask HS morphology as well as its diagnosis by osmotic fragility.
• 4. Gallstones: In approximately one-half of untreated patients; increased incidence with age, can occur as early as 4–5 years of age.
• LABORATORY FINDINGS
1.The hemoglobin level usually is 6–10 g/dL, but it can be in the normal range. The reticulocyte percentage often is increased to (3-15%).2. MCV usually decreased; mean corpuscular hemoglobin concentration (MCHC) raised .(36–38 g/dL) and RDW elevated.
• The presence of elevated RDW and MCHC makes the likelihood of
HS very high, because these two tests used together are very specific for HS
• 3.The RBCs on the blood film vary in size and include polychromatophilic reticulocytes and spherocytes. The spherocytes are smaller in diameter and appear hyperchromic on the blood film as a result of the high hemoglobin concentration. The central pallor is less conspicuous than in normal cells.
• 4.Erythroid hyperplasia is evident in the marrow aspirate or biopsy.
• 5. Osmotic fragility test: the RBCs are incubated in progressive dilutions of an iso-osmotic buffered salt solution. Exposure to hypotonic saline causes the RBCs to swell, and the spherocytes lyse more readily than biconcave cells in hypotonic solutions. This feature is accentuated by depriving the cells of glucose overnight at 37°C, known as the incubated osmotic fragility test. Unfortunately, this test is not specific for hereditary spherocytosis, and results may be abnormal in immune and other hemolytic anemias. A normal test result also may be found in 10–20% of patients.6.Autohemolysis at 24 and 48 h increased, corrected by the addition of glucose.
• 7.The specific protein abnormality can be established in 80% of these patients by RBC membrane protein analysis using
• gel electrophoresis and
• densitometric quantitation.
• The protein abnormalities are more evident in patients who have had a splenectomy.
• DIFFERENTIAL DIAGNOSIS
• large numbers of spherocytes are seen on the blood film in:
• Isoimmune and autoimmune hemolysis.
• Isoimmune hemolytic disease of the newborn, particularly due to ABO incompatibility, mimics hereditary spherocytosis. The detection of antibody on an infant's RBCs using a direct antiglobulin (Coombs) test should establish the diagnosis of immune hemolysis.
• Autoimmune hemolytic anemia also are characterized by spherocytes, and there may be evidence of previously normal values for hemoglobin, hematocrit, and reticulocyte count.
• Rare causes of spherocytosis include
• thermal injury,
• clostridial septicemia with exotoxemia, and
• Wilson disease,
• (each of which may present as transient hemolytic anemia )
• TREATMENT
• Because the spherocytes are destroyed almost exclusively in the spleen, splenectomy eliminates most of the hemolysis associated with this disorder. After splenectomy, the anemia, reticulocytosis, and hyperbilirubinemia resolve.• Whether all patients with hereditary spherocytosis should undergo splenectomy is controversial.
• Some do not recommend splenectomy for patients whose hemoglobin values exceed 10 g/dL and whose reticulocyte percentage is <10%.
• For patients with more severe anemia and reticulocytosis or those with hypoplastic or aplastic crises, poor growth, or cardiomegaly, splenectomy is recommended after age 5–6 yr to avoid the heightened risk of postsplenectomy sepsis in younger children.
• Laparoscopic splenectomy decreases the length of hospital stay and has replaced open splenectomy for many patients. Vaccines (conjugated and/or capsular) for encapsulated organisms, such as pneumococcus, meningococcus, and Haemophilusinfluenzae type b, should be administered before splenectomy, and prophylactic oral penicillin V (age <5 yr, 125 mg twice daily; age 5 yr through adulthood, 250 mg twice daily) administered thereafter.
• Partial splenectomy also may be useful in children younger than age 5 yr and can provide some increase in hemoglobin and reduction in the reticulocyte count, with potential maintenance of splenic phagocytic and immune function.
• Folic acid, 1 mg daily, should be administered to prevent deficiency and the resultant decrease in erythropoiesis.
Quiz
14 months old child presented to the outpatient with history of pallor, anorexia and ingestion of unusual substances
Feeding history: exclusive breast milk feeding
Q1: what are important investigation to be send?
Q2: how you treat this child? doses and duration